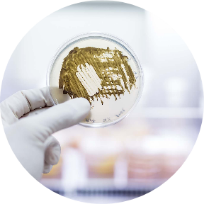

罕见病原体揭秘:一例肺部阴影探析惠普尔养障体感染



案例分享

5月前,呼吸与危重症医学科收治了一位青年男性患者,20天前可疑受凉后出现一过性畏寒、发热,之后反复咳嗽,咳少许白色粘液痰,症状持续20+天;院外口服了各种消炎药、止咳药,没啥效果。




以上是他的胸部CT影像,主要表现为左下肺炎症,片絮影+磨玻璃影。

治疗经过


考虑到患者使用多种抗生素效果不佳,肺部感染影像学改变明显,而症状却并不严重,主管医生判断该患者系不典型或者机会性肺部感染可能性大,于是立即安排了支气管镜检查,并送检肺泡灌洗液mNGS。

24小时后检查结果提示——惠普尔养障体感染。

惠普尔养障体感染是啥?


可能大家平时听说过什么细菌感染、病毒感染、支原体、衣原体感染,但多半没听说过惠普尔养障体感染,在日常生活中,肺炎是一种常见病,然而“惠普尔养障体肺炎”却非常少见。它的发病率低至亿分之一,鲜为人知。那么,这到底是一种什么样的疾病?
病因:
惠普尔养障体是一种革兰阳性杆菌,为条件致病菌,可引起罕见的多系统损害性疾病,以肠道症状为主,被称为“惠普尔病”。但在某些情况下,这种细菌也可能侵袭肺部,引发惠普尔养障体肺炎。这种类型的肺炎极为罕见,多见于经常接触污水、污土和免疫力较低的人群。惠普尔养障体肺炎的症状通常包括慢性咳嗽、发热、呼吸困难等,容易被误诊为其他类型的肺部感染,导致治疗延误。


环境分布与生长特性
环境生态位
主要存在于土壤、污水及动物粪便中,在污水处理厂活性污泥中检出率较高,提示其可能通过粪-口途径传播,在37℃潮湿环境中可存活数周,但对紫外线敏感。
苛刻培养要求
常规培养基无法生长,需使用特殊细胞培养系统(如人成纤维细胞系),倍增时间长达18天,这种缓慢生长特性导致临床分离培养极其困难,是确诊延迟的重要原因。
季节性分布特征
流行病学研究显示感染存在明显季节差异,温带地区夏秋季发病率较高,可能与气温升高促进环境中细菌增殖以及人类户外活动增加有关。

典型感染症状(肠道)
慢性腹泻与吸收不良
惠普尔病最具特征性的表现为持续性脂肪泻(每日5-15次恶臭泡沫状粪便),伴随肠道淋巴管扩张导致的蛋白质丢失性肠病,实验室检查可见低蛋白血症、低钙血症及维生素缺乏等营养不良表现。
腹痛与体重下降
约75%患者出现中上腹绞痛,呈间歇性发作;进行性体重减轻(平均下降10-20kg)是疾病标志,与肠道吸收功能障碍、慢性炎症消耗及食欲减退密切相关。
肠系膜淋巴结肿大
腹部CT可见肠系膜及腹膜后淋巴结显著增大(直径常>2cm),病理特征为泡沫状巨噬细胞浸润,PAS染色阳性,此表现对鉴别诊断具有重要价值。


肺部感染的影像学特征
多发性结节伴快速进展
CT表现为双肺多发实性结节(直径0.5-3cm),结节边缘可见毛刺征及分叶征,特征性表现为短期内体积呈几何级数增长(如1周内增大10倍),需与转移瘤、结核球等鉴别。
动态代谢活性变化
PET-CT显示结节SUVmax值显著升高(通常>5),但低于恶性肿瘤标准,且随治疗呈现"先升高后降低"的特殊代谢模式,反映肉芽肿性炎症的活动度演变过程。
混合性密度影与胸腔积液
约40%病例出现磨玻璃影与实变影共存,部分结节中央可见液化坏死;30%伴单侧渗出性胸腔积液,积液分析呈渗出性但培养阴性,此表现易误诊为脓胸。



全身多系统受累表现
关节病变
60-90%患者以游走性多关节炎为首发症状(膝关节最常见),表现为非侵蚀性、非畸形性关节肿痛,对非甾体抗炎药反应差但抗生素治疗有效,此特点有助于早期识别。
神经系统损害
晚期可出现认知障碍(记忆力减退、定向力丧失)、眼肌麻痹、肌阵挛等,脑脊液检查可见淋巴细胞增多(50-500/μl)及TW特异性PCR阳性,MRI显示颞叶内侧T2高信号颇具特征性。
心血管并发症
心包炎(超声见中大量心包积液)、心内膜炎(血培养阴性但赘生物病理阳性)及冠状动脉炎均可发生,其中无菌性心内膜炎可导致二尖瓣穿孔等严重结构破坏。


免疫功能低下易感因素
免疫抑制药物使用
长期使用糖皮质激素、免疫抑制剂(如器官移植患者)或生物制剂的患者,其巨噬细胞功能受损,无法有效清除惠普尔养障体,导致感染风险显著增加。
慢性疾病影响
HIV/AIDS、糖尿病、恶性肿瘤等慢性疾病患者因免疫系统功能低下,对惠普尔养障体的防御能力减弱,易发展为全身性感染,包括肺部侵袭。
老年人群生理衰退
老年人因胸腺萎缩、T细胞功能下降及黏膜屏障减弱,对病原体的清除能力降低,82岁病例的感染与此类年龄相关性免疫衰老密切相关。


病原体—宿主相互作用
免疫应答失衡
病原体可下调宿主Th1型免疫反应(如干扰素-γ分泌减少),同时诱导调节性T细胞过度活化,形成免疫耐受状态,促进慢性感染进程。
巨噬细胞逃逸机制
惠普尔养障体通过表面多糖胶囊抑制溶酶体融合,在巨噬细胞内长期存活并复制,形成"胞内寄生"模式,导致抗生素难以渗透至病灶。
组织特异性侵袭
肠道为原发感染部位,但菌体可通过血流播散至肺、关节及中枢神经系统,肺部感染时表现为肺泡巨噬细胞大量浸润和肉芽肿形成。
§ 

§
§

慢性感染与复发机制
生物被膜形成
惠普尔养障体在肺组织内可形成生物被膜,导致抗生素渗透障碍,即使完成初始治疗,残留菌体仍可能引发复发,需长达12个月的巩固治疗。
基因多态性影响
宿主HLA-B27等位基因携带者可能因抗原提呈异常,导致病原体清除延迟,临床表现为反复发作的关节炎和肺部炎症。
免疫重建综合征
免疫功能恢复过程中(如HIV患者接受ART治疗后),过度炎症反应可能激活潜伏感染的惠普尔养障体,表现为治疗后的病情"反跳"现象。



抗生素治疗方案选择
联合用药策略
首选头孢曲松(2g/日静滴)联合多西环素(100mg bid口服)的14天强化方案,穿透血脑屏障效果佳,对合并神经系统感染者尤为适用。替代方案包含复方磺胺甲恶唑(TMP-SMX)联合羟氯喹调节巨噬细胞功能。
疗程个体化调整
单纯肺部感染需持续治疗3-6个月,合并肠型惠普尔病或中枢感染时延长至12个月。治疗期间需监测肝功能异常等药物不良反应,必要时切换为美罗培南静脉用药。
耐药性管理
惠普尔养障体对氟喹诺酮类天然耐药,临床应避免使用左氧氟沙星等药物。对β-内酰胺类过敏患者可选用四环素类替代,但需注意儿童及孕妇禁忌。


明确诊断后我们给予了正规治疗,患者咳嗽症状迅速缓解,1月后复查胸部CT提示肺部病变大部分吸收。


4月后再次复查胸部CT,提示病灶已经完全吸收。
惠普尔养障体肺部感染属于罕见疾病,在目前的医疗条件下,我们完全能够做到准确的识别和有效的治疗;由于该病菌顽固难缠,患者通常需要进行长期的抗生素治疗,持续数月甚至一年以上,才能彻底清除体内的感染。


今天的分享就到这里啦!
我们下期再见!

作者:王丰
编辑:唐红萍
审核:马升军
部分图片来源于网络,侵权即删!

